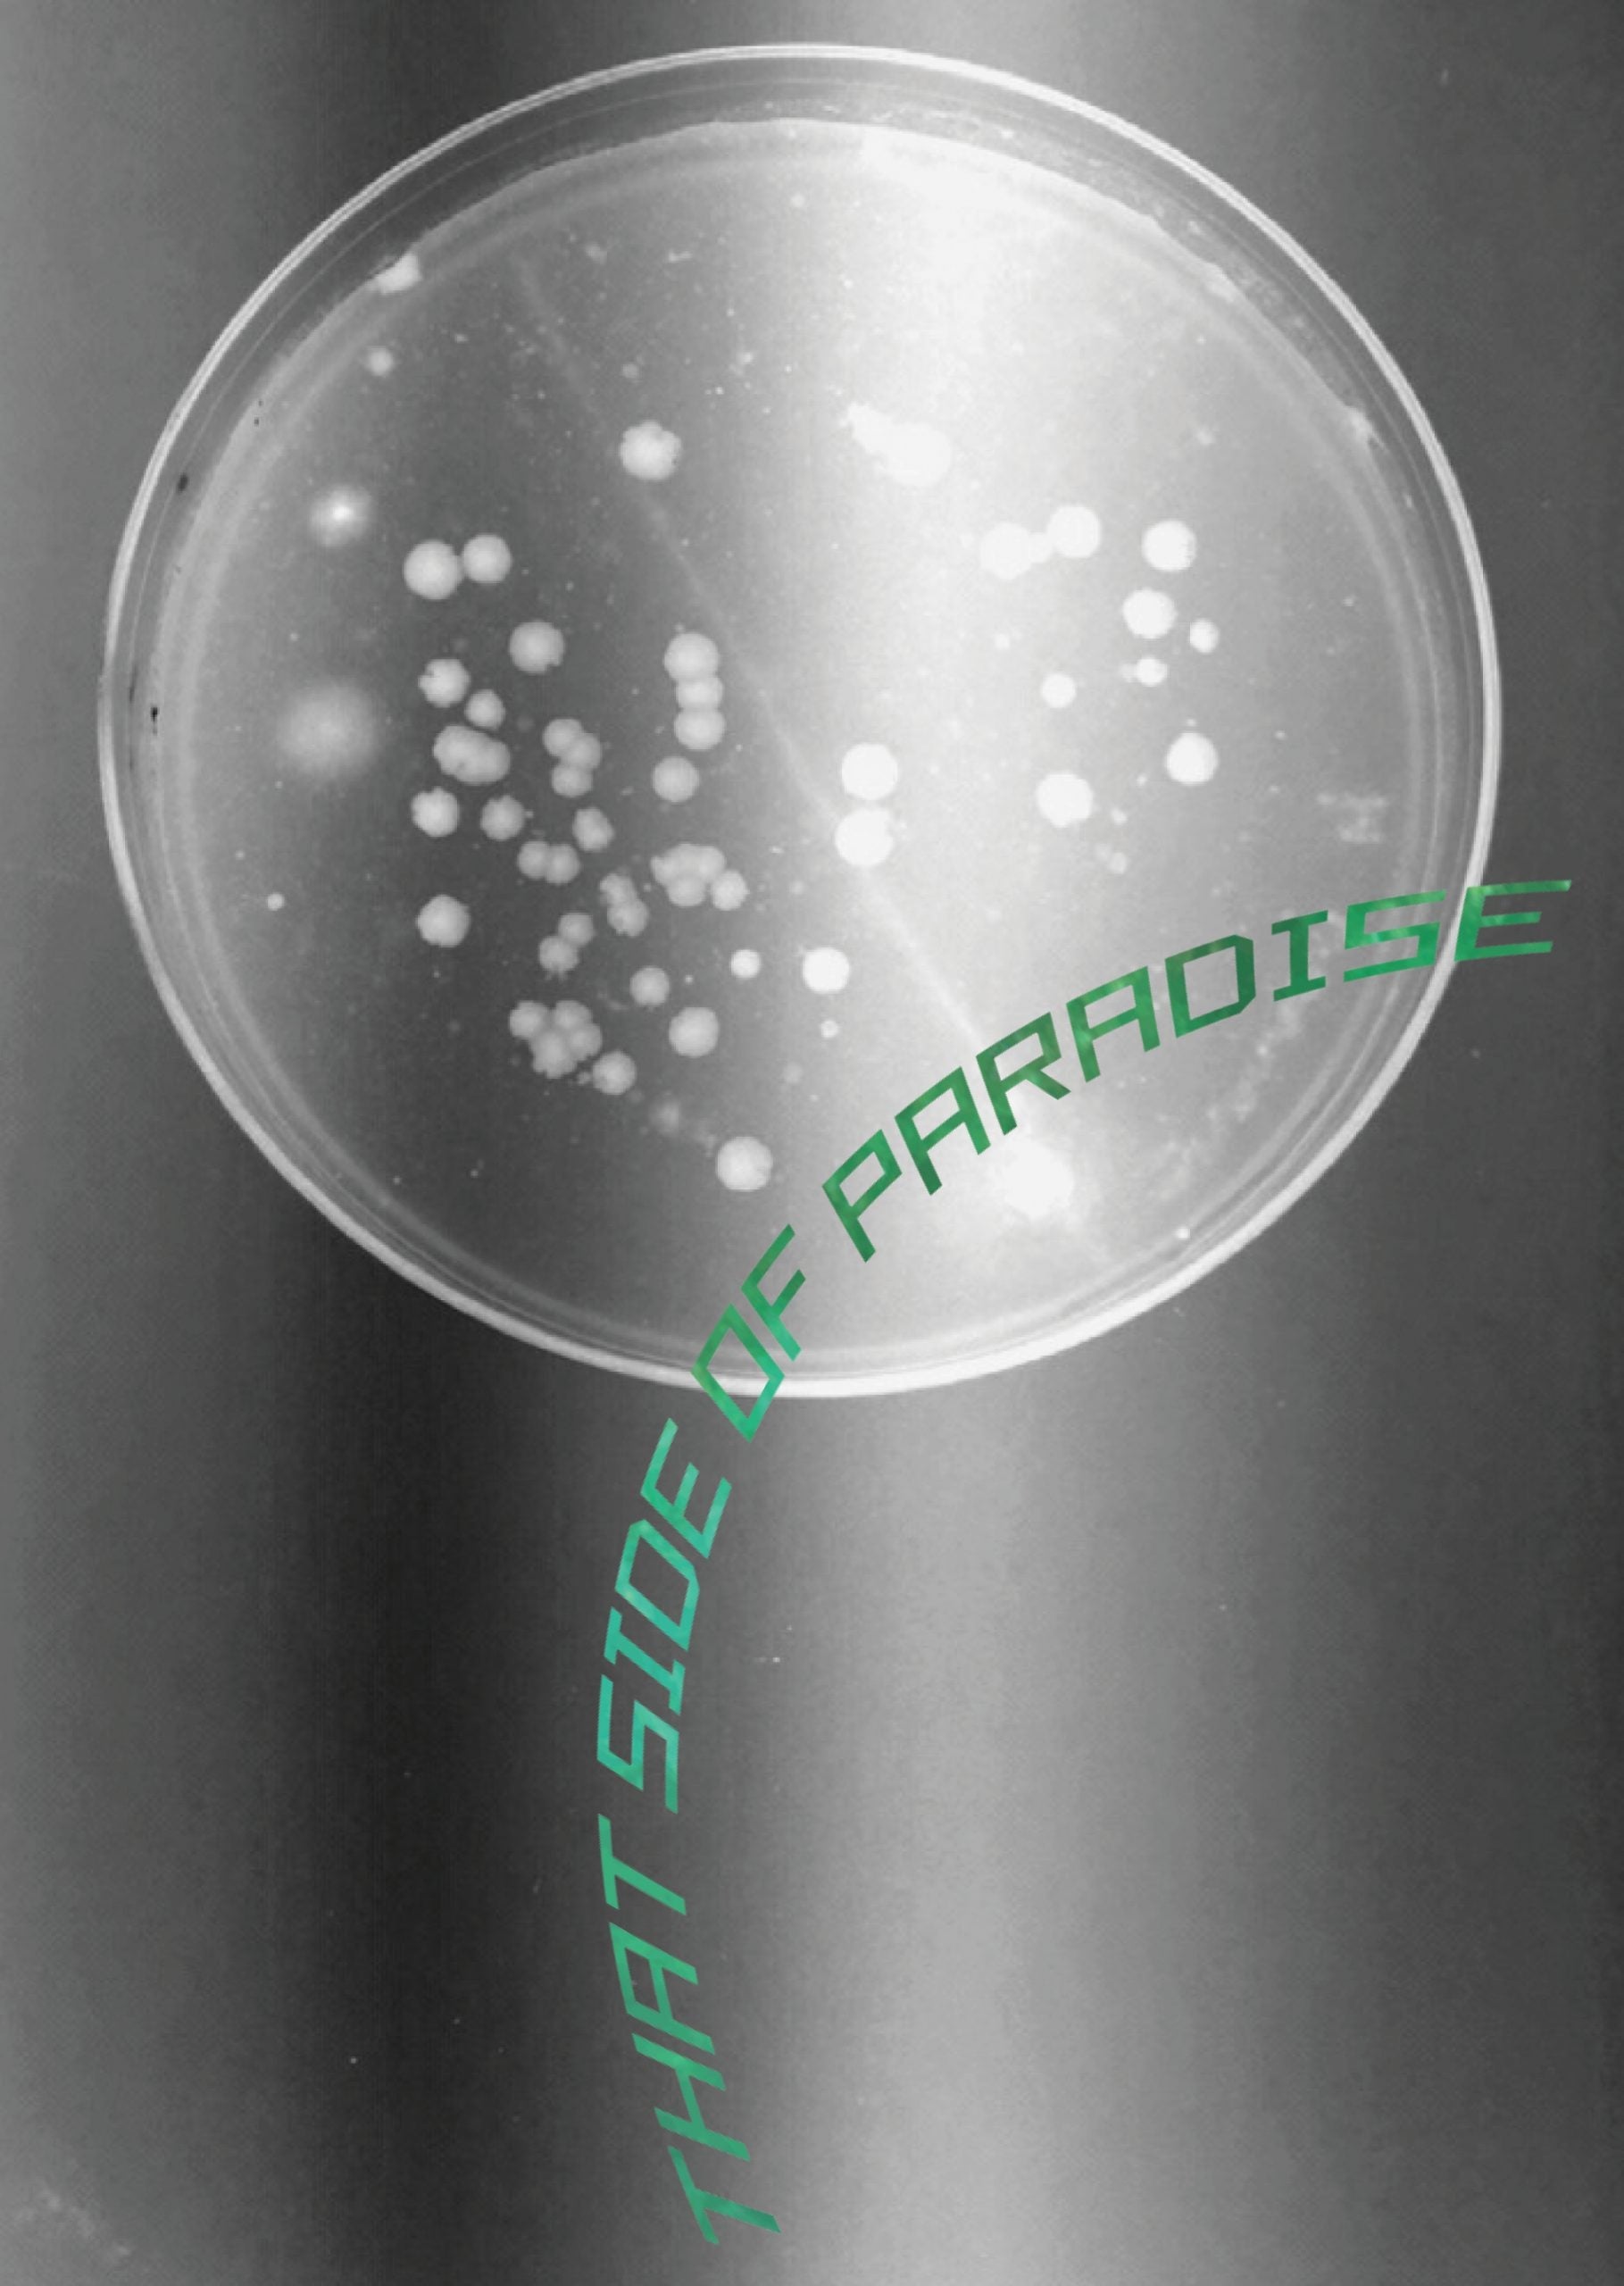

Broken Pencil
Seagery Zine #3: That Side of Paradise
Quantity:
Created by Katrina Vera Wong of Vancouver, British Columbia. Nominated for Best Group Zine & Collab at the Broken Pencil Zine Awards 2020. Exploring paradise and what it takes to make it or save it. 68 pages with beautiful written and visual contributions from Ali Massie, Deborah Wong, Katrina Vera Wong, Syed Mustafa, Ellen Hall, Deuphine Apedaile, Raymond Nakamura, Yana Zorina, William Tham, Qinrui Chen, Cleomë Wilkinson, Heun Jung Kim, W.B., Courtney Chaney, Larissa Blokhuis, Paige Whitehead, Vincent Ternida, Emily Tamsin, Kodai Yanagawa, Henrieta Lau, Mercy A. Lee, and JT Lee. And interviews with artist Ani Liu, sculptor Jason deCaires Taylor, Titouan Bernicot (founder of Coral Gardeners), Richard Vevers (founder of The Ocean Agency), Dirk Petersen (executive director and founder of SECORE Intl.), and Anastazia Banaszak (SECORE’s local lead coral biologist in Puerto Morelos).